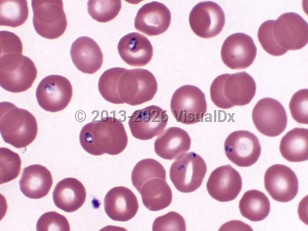

Babesiosis
Alerts and Notices
Important News & Links
Synopsis

Babesiosis is a tick-borne zoonotic infection caused by protozoa of the genus Babesia. The major tick vector in the United States is Ixodes scapularis (blacklegged ticks, or deer ticks), which can also transmit Lyme disease, human granulocytic anaplasmosis (formerly known as human granulocytic ehrlichiosis), and Borrelia miyamotoi. Concomitant infections with these pathogens have been described. The main animal reservoir is the white-footed mouse. Babesia species, like Plasmodium, are obligate intracellular parasites of erythrocytes and may cause a malaria-like syndrome of fever and hemolysis.
Babesiosis due to Babesia microti is highly endemic in the following states: Connecticut, Massachusetts, New York, New Jersey, Rhode Island, Wisconsin, and Minnesota. Cases are also sporadically reported from many other states including Maine, Maryland, New Hampshire, and Vermont. Babesia duncani and a B duncani-like species have been implicated in human babesiosis cases in the Pacific Northwest region of the United States. Sporadic cases have been noted in other parts of the United States. Babesia divergens occurs in Europe, and other species appear to cause sporadic disease in South America, Asia, and North Africa. Babesiosis can be transmitted via transfusion of contaminated blood products and, rarely, transplacentally.
Babesia species have a complex life cycle that includes asexual reproduction in mammalian host erythrocytes and sexual reproduction in tick vectors. The sporozoite form is injected into the skin of humans by a feeding tick. In erythrocytes, Babesia trophozoites reproduce by binary fission. Two or four merozoites are produced. If four remain close together, this merozoite tetrad form may be seen on Giemsa- or Wright-stained thin smears of blood (as the pathognomonic "Maltese cross"). The emergence of merozoites from erythrocytes causes cell lysis, and new infection of red blood cells ensues. Hemolytic anemia may develop, accompanied by tissue hypoxia. Autoimmune hemolytic anemia may also occur.
Immunocompromised patients, particularly surgically or functionally asplenic individuals, are more likely to develop symptomatic disease and severe disease. Other risk factors for severe babesiosis include age older than 50 years; cancer; HIV infection; organ transplantation; hemoglobinopathy; chronic heart, lung, or liver disease; and receipt of immunomodulatory agents.
The incubation period post-tick bite is 1-6 weeks but may be as long as 9 weeks in transfusion-related infection. Infections are asymptomatic or mild in most immunocompetent individuals. Most symptomatic infections are mild and self-limiting and present as a nonspecific viral-like illness characterized by gradual onset of fatigue, malaise, and fever and one or several of the following symptoms: chills, sweats, headache, myalgia, arthralgia, anorexia, cough, and nausea. There are few findings on physical examination except for fever and occasionally mild splenomegaly, hepatomegaly, or both. Fever may be absent in immunocompromised patients. With the exception of petechiae and ecchymoses in severe infection, other skin manifestations are not observed.
Complications of more severe infection include acute respiratory failure, disseminated intravascular coagulation, congestive heart failure, lethargy, coma, and renal failure. Mortality rates of 6%-9% have been reported in patients with severe infection. Most of these cases were in patients older than 50 years and with significant comorbidities. Relapse of hemolytic anemia and symptoms is uncommon in treated and otherwise healthy patients, even though parasitemia may persist for over 1 year. Relapsing or persistent disease despite treatment may occur in immunosuppressed individuals.
Babesiosis due to Babesia microti is highly endemic in the following states: Connecticut, Massachusetts, New York, New Jersey, Rhode Island, Wisconsin, and Minnesota. Cases are also sporadically reported from many other states including Maine, Maryland, New Hampshire, and Vermont. Babesia duncani and a B duncani-like species have been implicated in human babesiosis cases in the Pacific Northwest region of the United States. Sporadic cases have been noted in other parts of the United States. Babesia divergens occurs in Europe, and other species appear to cause sporadic disease in South America, Asia, and North Africa. Babesiosis can be transmitted via transfusion of contaminated blood products and, rarely, transplacentally.
Babesia species have a complex life cycle that includes asexual reproduction in mammalian host erythrocytes and sexual reproduction in tick vectors. The sporozoite form is injected into the skin of humans by a feeding tick. In erythrocytes, Babesia trophozoites reproduce by binary fission. Two or four merozoites are produced. If four remain close together, this merozoite tetrad form may be seen on Giemsa- or Wright-stained thin smears of blood (as the pathognomonic "Maltese cross"). The emergence of merozoites from erythrocytes causes cell lysis, and new infection of red blood cells ensues. Hemolytic anemia may develop, accompanied by tissue hypoxia. Autoimmune hemolytic anemia may also occur.
Immunocompromised patients, particularly surgically or functionally asplenic individuals, are more likely to develop symptomatic disease and severe disease. Other risk factors for severe babesiosis include age older than 50 years; cancer; HIV infection; organ transplantation; hemoglobinopathy; chronic heart, lung, or liver disease; and receipt of immunomodulatory agents.
The incubation period post-tick bite is 1-6 weeks but may be as long as 9 weeks in transfusion-related infection. Infections are asymptomatic or mild in most immunocompetent individuals. Most symptomatic infections are mild and self-limiting and present as a nonspecific viral-like illness characterized by gradual onset of fatigue, malaise, and fever and one or several of the following symptoms: chills, sweats, headache, myalgia, arthralgia, anorexia, cough, and nausea. There are few findings on physical examination except for fever and occasionally mild splenomegaly, hepatomegaly, or both. Fever may be absent in immunocompromised patients. With the exception of petechiae and ecchymoses in severe infection, other skin manifestations are not observed.
Complications of more severe infection include acute respiratory failure, disseminated intravascular coagulation, congestive heart failure, lethargy, coma, and renal failure. Mortality rates of 6%-9% have been reported in patients with severe infection. Most of these cases were in patients older than 50 years and with significant comorbidities. Relapse of hemolytic anemia and symptoms is uncommon in treated and otherwise healthy patients, even though parasitemia may persist for over 1 year. Relapsing or persistent disease despite treatment may occur in immunosuppressed individuals.
Codes
ICD10CM:
B60.00 – Babesiosis, unspecified
SNOMEDCT:
21061004 – Babesiosis
B60.00 – Babesiosis, unspecified
SNOMEDCT:
21061004 – Babesiosis
Look For
Subscription Required
Diagnostic Pearls
Subscription Required
Differential Diagnosis & Pitfalls

To perform a comparison, select diagnoses from the classic differential
Subscription Required
Best Tests
Subscription Required
Management Pearls
Subscription Required
Therapy
Subscription Required
References
Subscription Required
Last Updated:02/08/2023
Babesiosis